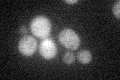
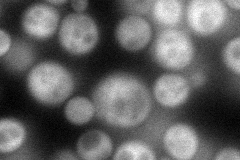
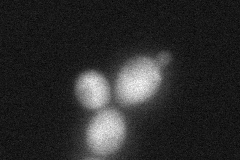
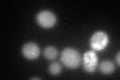
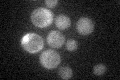

View description
Pyruvate kinase that appears to be modulated by phosphorylation; PYK2 transcription is repressed by glucose, and Pyk2p may be active under low glycolytic flux
Localization:
Intensity:
Fold change:
Significance:
-
C’ GFP library in SD
cytosol25.42 -
N' NOP1pr-GFP in SD
cytosol100.199 -
N' TEF2pr-mCherry in SD

cytosol0 -
N' NATIVEpr-GFP in SD

cytosol34.1493 -
N' TEF2pr-VC and Cyto-VN in SD
cytosol53.1681 -
C’ GFP library in SD+DTT
cytosol41.661.63Yes -
C’ GFP library in SD+H2O2

cytosol30.991.21No -
C’ GFP library in Starvation Media
cytosol26.671.04No -
C’ GFP library on the background of Pup2-DaMP

cytosol -
C’ GFP library on the background of CCT mutant

cytosol27.12961.06692No
